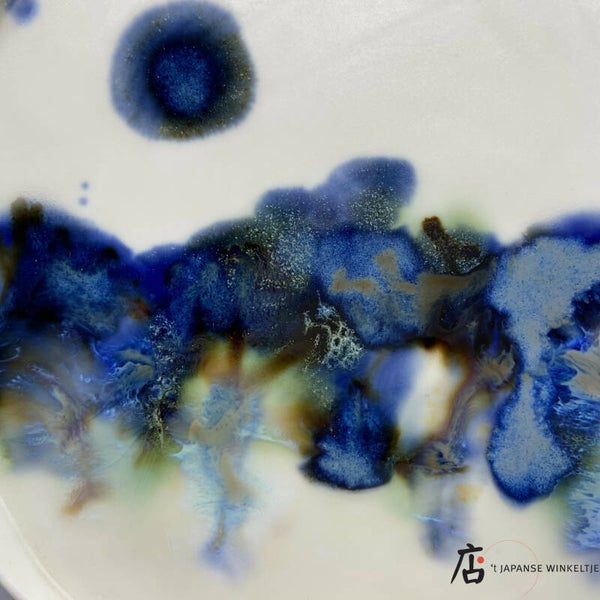

Chuzara (中皿) schaal/bord Ø 20~21 cm "Forest Night" M (K-Haru-32A)
Uitverkocht
€ 49,95
Handgemaakt door pottenbakster Haruka Matsuo. Hierdoor is er maar een exemplaar dat er precies zo uitziet.
De schildering moet een impressie voorstellen van een bos bij nacht. De blauwe stip links bovenin is de maan.
Deze schaal kan gebruikt worden voor sushi, voor zoete en/of hartige lekkernijen of als fruitschaal.
Type: chuzara, schaal/bord
Afmetingen: diameter 20~21 cm, ca. 1,3~1,5 cm hoog
Kleur: bruin, blauw, groen, wit
Productnummer: K-Haru-32A